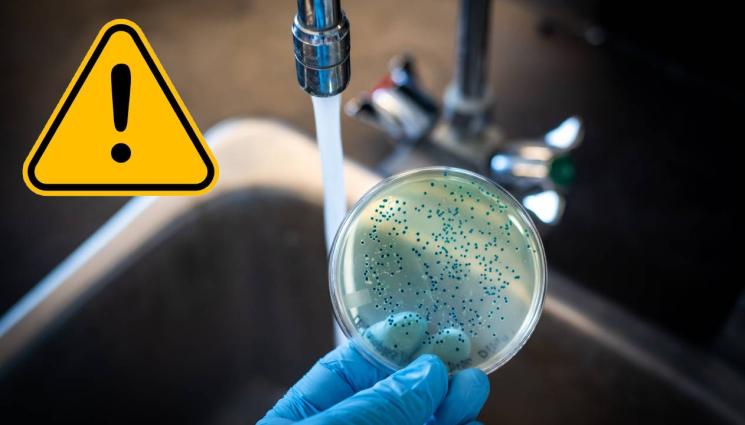
d - Светът се изправя пред засилваща се чума от холера

С ветовната здравна организация предупреди за влошаване на ситуацията с холерата, с огнища в 31 държави и растяща смъртност.
ПАНДЕМИЯТА ЧУКА НА ВРАТАТА? Една от най-смъртоносните болести плъзна в 23 държави!
„Поради мащаба, тежестта и взаимната свързаност на тези огнища, рискът от по-нататъшно разпространение вътре в страните и между тях е изключително висок“, заявиха от организацията.
Според ООН, влошаването на ситуацията се дължи на конфликти и бедност, като най-уязвими са селските райони и райони, засегнати от наводнения. Холерата е остра чревна инфекция, разпространявана чрез храна и вода, замърсени с бактерии, често от изпражнения.
От 1 януари до 17 август Световната здравна организация е регистрирала 409 222 случая и 4 738 смъртни случая по света. Въпреки че случаите са с 20% по-малко в сравнение със същия период на миналата година, смъртността е нараснала с 46%.
Холерата набира скорост в няколко държави, които години наред не са регистрирали значителен брой случаи, като Република Конго и Чад, където в момента се отчитат най-високи смъртни проценти — съответно 7,7% и 6,8%.
Без адекватно лечение холерата може да убие за часове, но обикновената орална рехидратация и антибиотиците при по-тежки случаи са ефективни.
От 2021 г. се наблюдава глобално увеличение на случаите на холера и разширяване на географското ѝ разпространение, предаде БГНЕС.